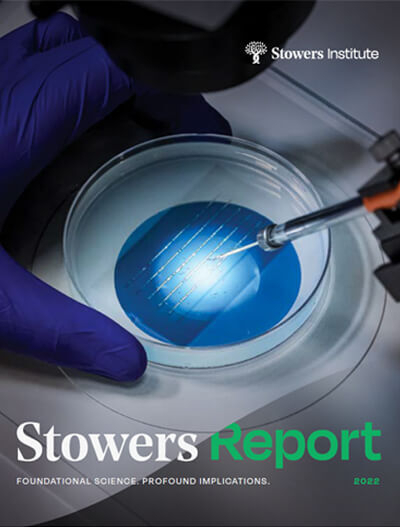
Petri dish
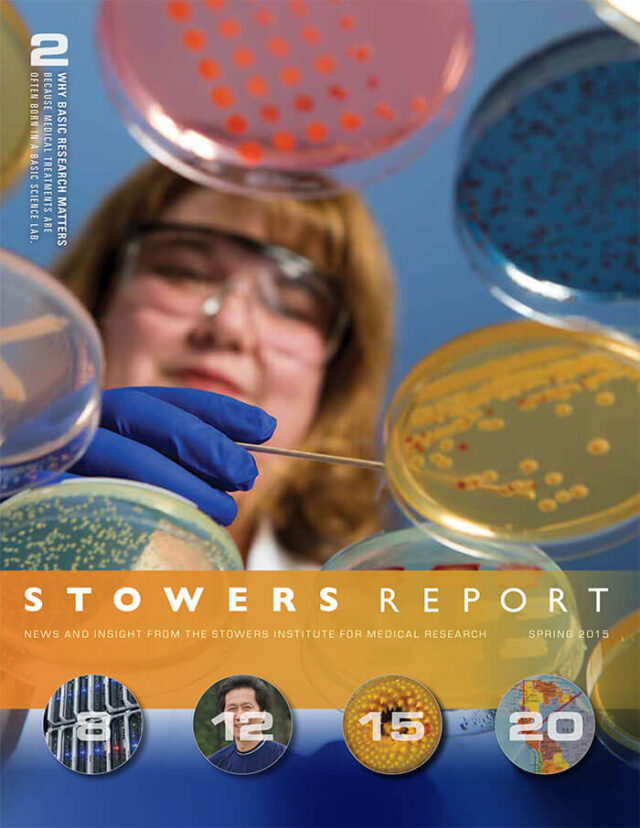
Cover of the 2015 Spring Stowers Report, the newsletter of the Stowers Institute

2024
The 2024 Stowers Report celebrates some of the incredible contributions our scientists, students, and staff have achieved this past year, including collaborations, science, and innovations that contribute to our better understanding of the secrets underlying fundamental biological processes.
View Report